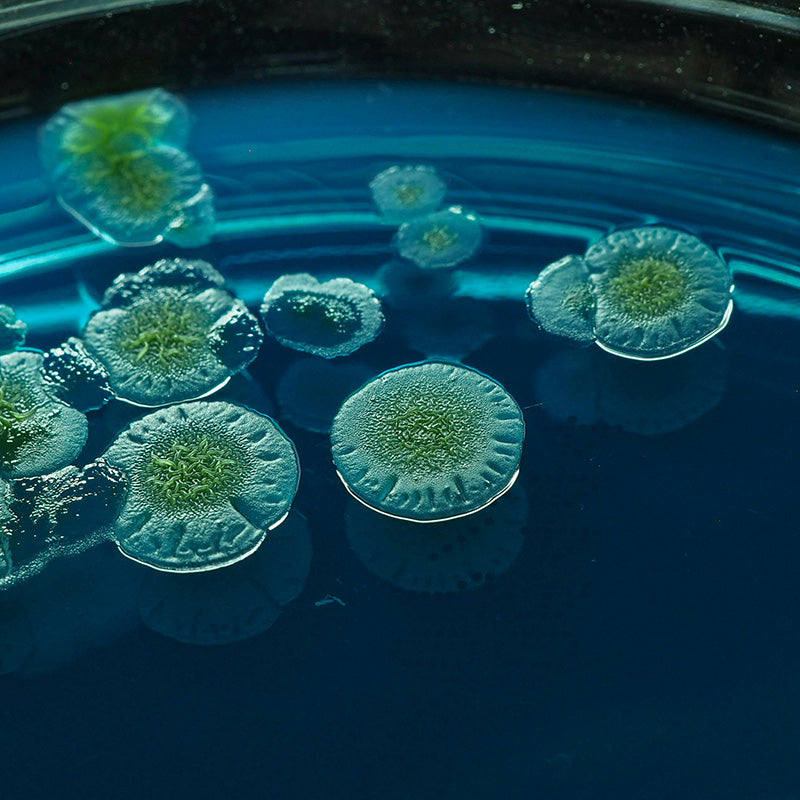

No-Fenol
Improves the breakdown of fruits and vegetables
- Helps support availability of polyphenols from foods
- Partially breaks down fiber during digestion, allowing incorporation into stool†
- Contains cellulose and medium-chain triglyceride powder for dust control of the enzyme powder.
- HN003-S90 | 90 capsules (90 doses)
nlock Vital Nutrients Boost Digestive Comfort Make The Right Choice Do What’s Right For Your Gut Health U
No Fenol
No-Fenol™️ was developed by Dr. Devin Houston, Founder and CEO of Houston Enzymes, in response to requests for a product that would support the digestion of fruits and vegetables, especially those high in polyphenolic compounds.
No-Fenol™️ helps digestion by supporting the breakdown of the fibrous plant cell walls of fruits and vegetables, allowing the polyphenols and other cell nutrients to be released during digestion.
All plants contain some amount of polyphenolic compounds (sometimes called "phenols"). The polyphenol structure itself is found everywhere in nature, and is essential to many of life's processes. Some individuals have difficulty in the processing of foods high in polyphenolic compounds.
Polyphenols are important compounds used by gut bacteria. The research literature indicates that some polyphenols, when produced in the plant, are modified by the addition of carbohydrate groups to their structures, which may inhibit their availability for absorption. Enzymes, such as alpha-glucosidases, found in gut bacteria can de-glycosylate the polyphenols (remove the carbohydrate group) which then supports absorption of the compound.
The enzyme xylanase is the major component of No-Fenol, and is an enzyme used to breakdown the structural components of plant cell walls, which are primarily complex carbohydrates. Xylanase is used in the juice industry to extract more juice from fruit pulp fibers.
The enzymes in No Fenol offer support for digestive issues caused by:
- Fruits
- Vegetables
- Coffee
- Tea
- Nuts
- Seeds
- Other Foods High in Polyphenols
No-Fenol™️ was developed by Dr. Devin Houston, CEO of Houston Enzymes, in response to requests for a product that would support the digestion of fruits and vegetables, especially those high in polyphenolic compounds.
All plants contain some degree of polyphenolic compounds (sometimes called "phenols"). The polyphenol structure itself is found everywhere in nature, and is essential to many of life's processes. Some individuals have difficulty in the processing of foods high in polyphenolic compounds.
Polyphenols are important compounds used by the gut bacteria.The research literature indicates that some polyphenols, when produced in the plant, are modified by the addition of carbohydrate groups to their structures, which may inhibit their availability for absorption. Enzymes, such as alpha-glucosidases, found in gut bacteria can de-glycosylate (removing the carbohydrate group) the polyphenols which then supports absorption of the compound.
No-Fenol may help digestion by breaking down the fibrous plant cell walls of fruits and vegetable, allowing the polyphenols and other cell nutrients to be released during digestion.
The enzyme xylanase is the major component of No-Fenol, and is an enzyme used to breakdown the structural components of plant cell walls, which are primarily very complex carbohydrates. Xylanase is used in the juice industry to extract more juice from fruit pulp fibers.
Foods rich in polyphenols include:
- Brightly colored fruits
- Brightly colored vegetables
- Red wine
- Coffee
- Black and green teas
- Spices
- Dark chocolate
Filler
No-Fenol capsules contains microcrystalline cellulose and medium chain triglyceride (MCT) powder as filler. The MCT is derived from palm or coconut oil, and the cellulose is derived from European Spruce trees.
You may open the No-Fenol capsules and mix with food or drink. Also check out our TriEnza Chewable which has some of the main enzyme from No-Fenol, plus other enzymes for carbs, fats and proteins.
Contraindications for Enzyme Supplementation
This product may not be appropriate for those with known allergies to enzyme proteins, though non-specific mold allergies do not necessarily preclude use of fungal enzymes. Consult your medical doctor for further advice, and err on the side of caution. Those with known anaphylactic allergic reactions to fungal proteins should NOT ingest fungal-derived enzymes.
A dose of 1 capsule usually suffices for most meals, but not necessarily with every meal. Some have found satisfactory results with once or twice per day dosing, indicating that optimal dosing may be dependent upon many factors.
Supplement Facts:
Serving Size: 1 Capsules
Servings per Container: 90
Ingredients:
Enzyme Blend: 207 mg (Amount Per Serving)*
Xylanase: 25,000 XU (Amount Per Serving)*
Galactomannanase (AN): 340 GU (Amount Per Serving)*
*Daily Value Not Established
Other Ingredients:
Capsule (cellulose and water), microcrystalline cellulose and medium chain triglyceride powder.
This product includes the following materials that are either derived from or contain allergens which must be declared on labels per the US Food Allergen Labeling and Consumer Protection Act (FALCPA):
None‡.
The production process used to manufacture the enzymes found in this product utilizes fermentation materials that are derived from or contain the allergens listed below. While these fermentation materials should be either consumed during fermentation or removed from the enzyme during additional enzyme isolation steps, minute traces of these allergens may be left in the final enzyme product. While these traces are expected to be below the limits of detection for standard ELISA based allergen testing methods‡, we cannot guarantee the complete absence of these allergens:
Wheat
‡NOTE: Enzymes and probiotics can interfere with common ELISA based allergen test kits, producing either false positives or false negatives in these tests. When performing allergen testing on enzyme containing products, special sample preparation techniques must be utilized to avoid this interference.
Can I receive a sample?
Yes. To request a free sample within the US, contact us by emailing info@houston-enzymes.com, or calling 866-757-8627.
Can I take No-Fenol with my medications?
No-Fenol can be taken with most medications. However, caution should be exercised when using sustained-release medications that use cellulose as part of the time-release mechanism, as it may affect dosing. It should be noted that no study has yet been carried out to detemine whether this action actually occurs.†
Will taking oral enzymes cause my pancreas to stop making enzymes?
No. Studies have shown little or no effect of oral enzymes on pancreatic enzyme production. The pancreas enzyme production is not regulated by a feedback system, and has no way of determining whether you are taking oral enzymes.
What is the dosing for No-Fenol?
No one dose is suitable for all. Dosing is not calculated based on age or body weight, but by how much is eaten in any one meal. Large meals or meals with foods that may not be well-tolerated, may require higher levels of enzyme. We encourage some experimentation to find the amount that works best for you. A dose of ½ to 1 capsule per meal seems to be fine for most, and we recommend a limit of 3 capsules taken at any one time.†

Harnessing the Power of Natural Enzymes
Enzymes are essential proteins that speed up biochemical reactions in the body, crucial for functions like digestion, metabolism, and immune response. They enhance nutrient absorption, energy production, and toxin elimination. By breaking down food molecules, enzymes support gut health and overall well-being. Simply put, enzymes are vital for maintaining optimal health and bodily function.
The Science Behind Enzyme Supplements
Many enzyme supplements are derived from natural sources like plants and microorganisms, cultivated in controlled lab environments for purity. These enzymes undergo rigorous testing to verify their activity and effectiveness, including measuring their ability to break down specific substances. We at Houston Enzymes prioritize quality, utilizing advanced technologies to produce safe and beneficial enzyme supplements that can help boost your health.

Do what's right for your gut health
Shop Other Enzymes
†These statements have not been evaluated by the Food and Drug Administration. This product is not meant to diagnose, treat, cure, or prevent any disease.